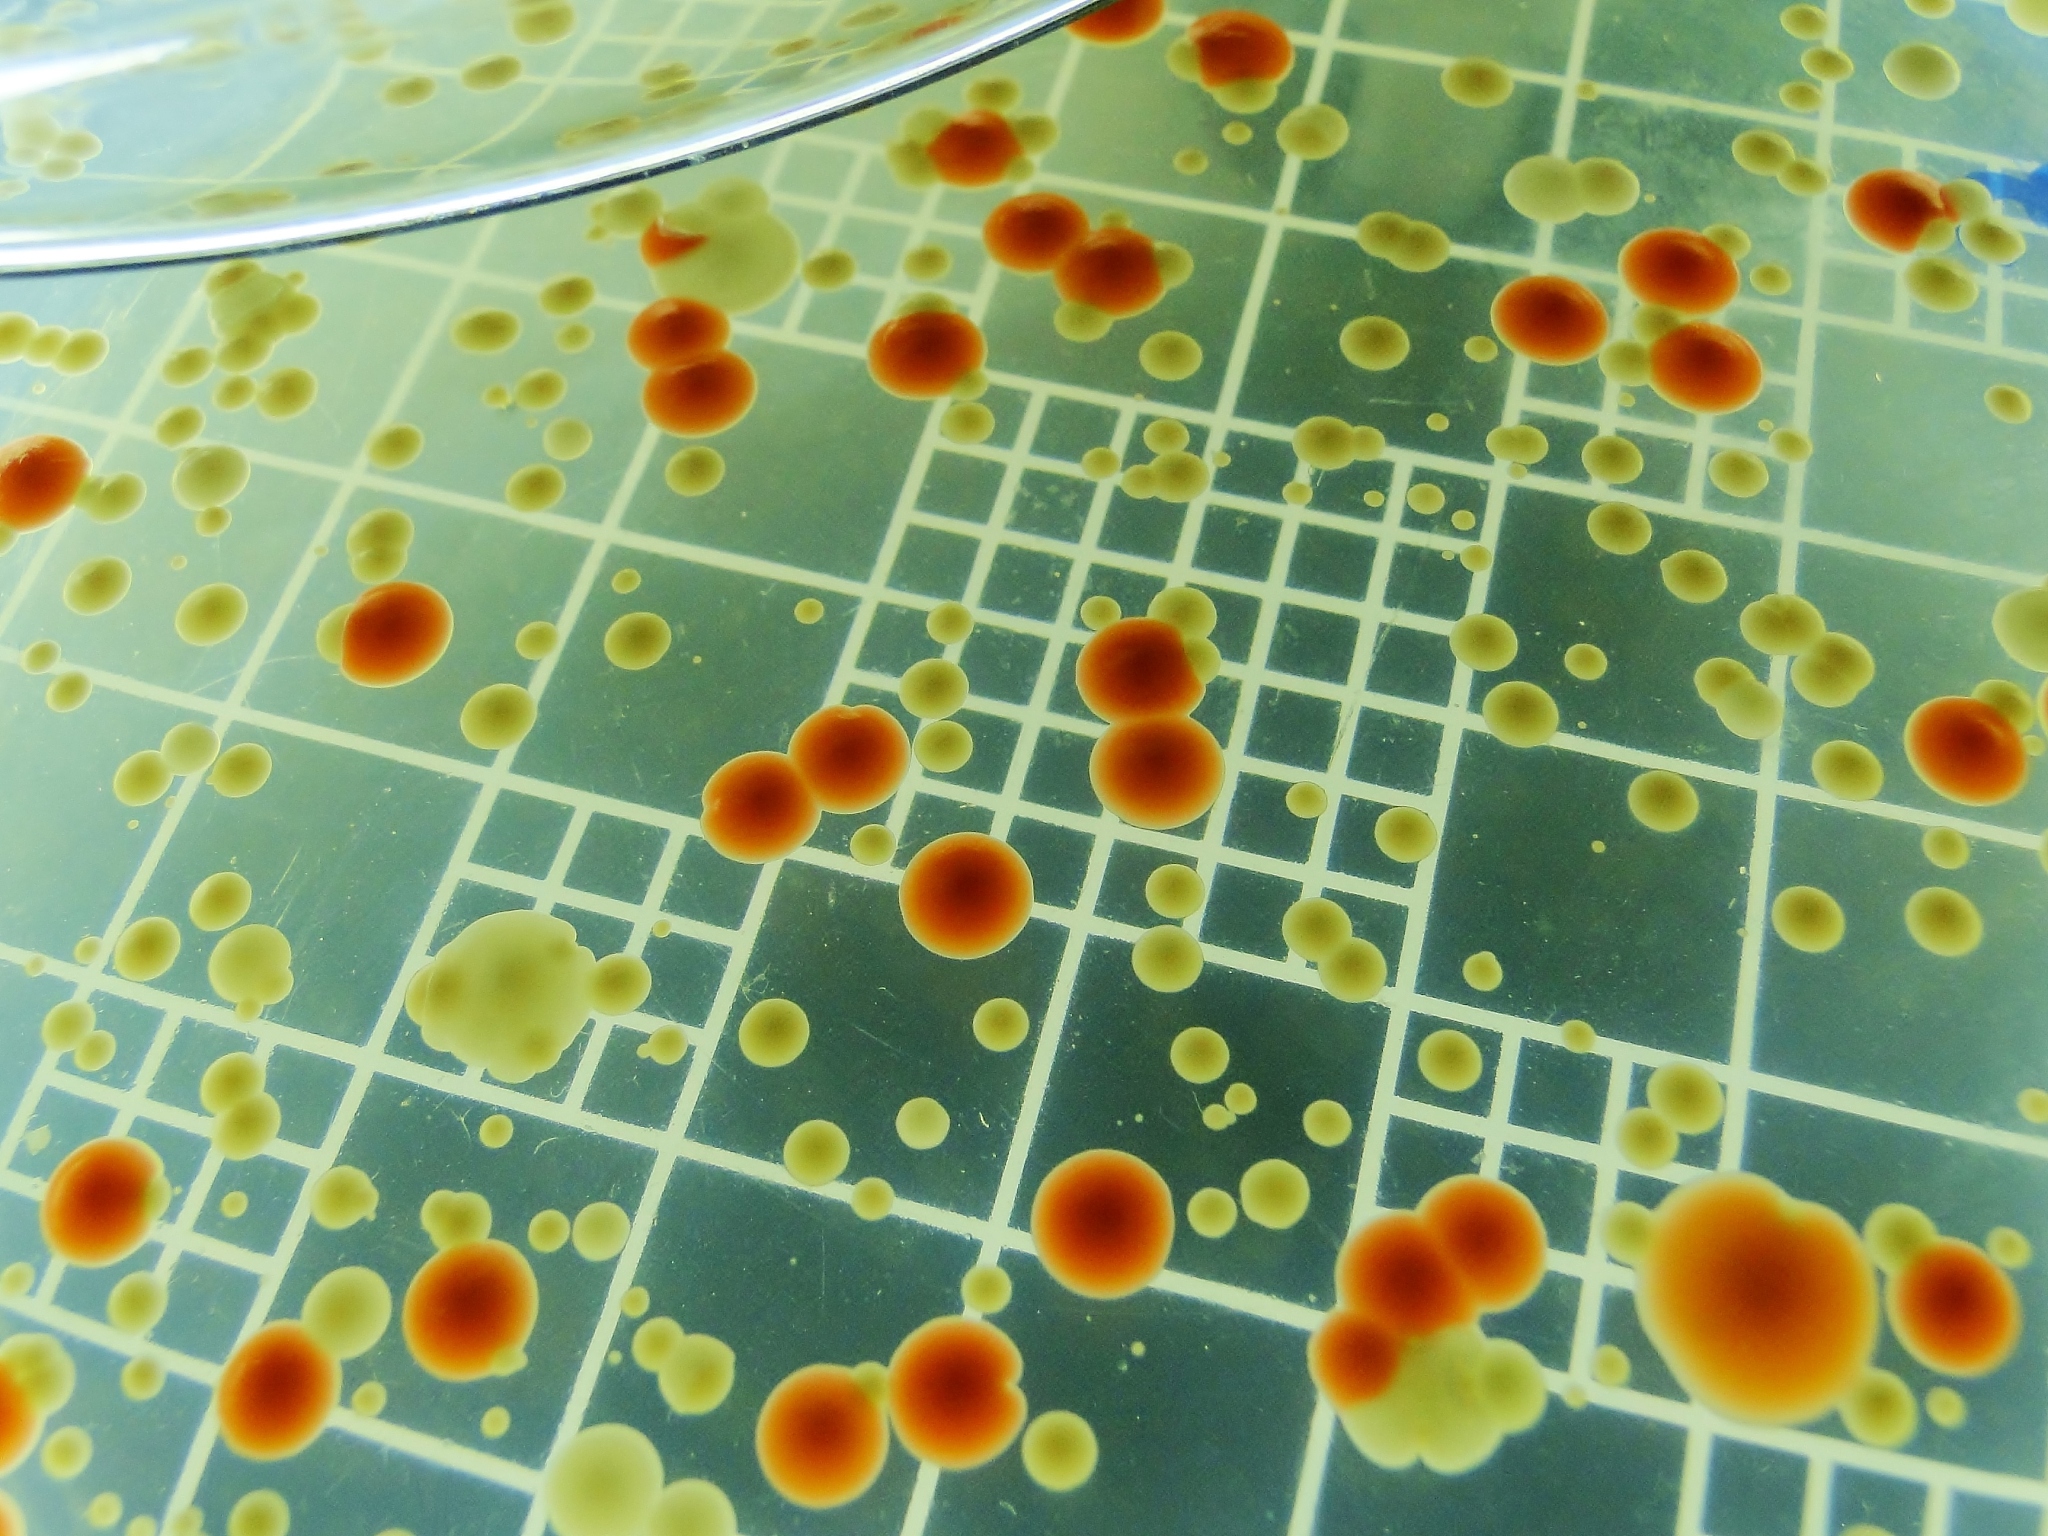
可以用来配置电子显微镜的正染色液的化学药品有哪些？

可以用来配置电子显微镜的正染色液的化学药品有哪些?
常用的电子显微镜正染色液的化学药品包括:
-
乙酸铀:常用的电子显微镜正染色剂,可以使细胞和组织中的核酸和核蛋白质等分子结构显得更加明显。
-
铀酸钠:也是一种常用的正染色剂,可以使细胞和组织中的核酸等分子结构显得更加清晰。
-
溴甲酚蓝:可以染色细胞和组织中的胞质,使细胞和组织的结构更加清晰。
-
木炭黑:可以染色细胞和组织中的细胞质和细胞器,使其更加明显。
-
酸性染料(如eosin):可以染色细胞和组织中的蛋白质,使其更加清晰。
-
尼格霉素:可以染色细胞和组织中的核糖体,使其更加明显。
-
塔氏液:可以染色细胞和组织中的胞质和细胞器,使其更加清晰。
原文地址: https://www.cveoy.top/t/topic/ffHI 著作权归作者所有。请勿转载和采集!